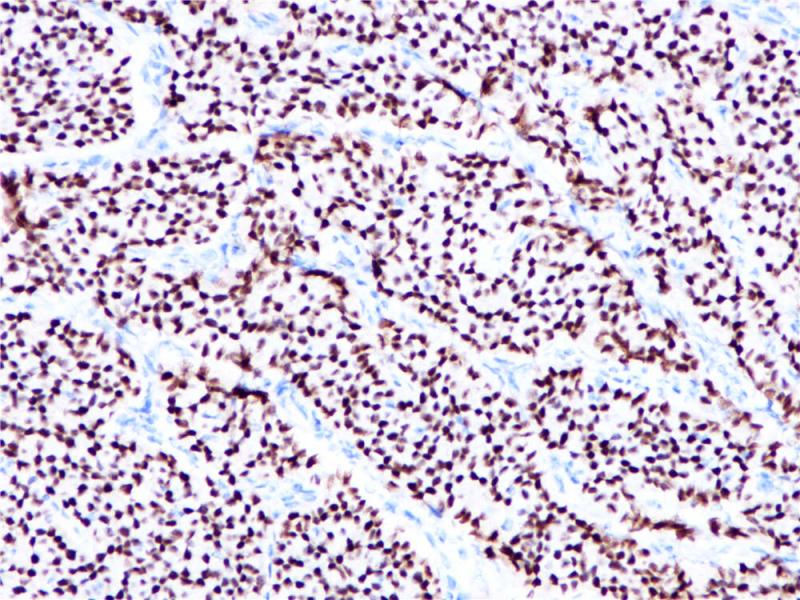
乳腺癌 ERα(+) (BP6026) 染色

产品中心
乳腺癌 ERα(+) (BP6026) 染色

乳腺癌 ERα(-) (BP6026) 染色
Estrogen Receptor α 重组兔单克隆抗体
雌激素受体(ER)属于核受体超家族的类固醇受体,由553个氨基酸组成。雌激素受体分子具有三个结构域,即DNA结合中央结构域,C末端的激素结合结构域和N末端的转录激活结构域。ER参与女性性激素的调节功能,主要是17(E2),在一些目标组织的生长、分化和功能方面,如女性和男性生殖道,乳腺,骨骼和心血管系统。ER α存在于正常乳腺和子宫内膜组织的上皮细胞的细胞核,以及乳腺癌的亚型中。其次, ER α可作为一个肿瘤标志物,与抗孕酮受体的抗体组合,可用于腺癌的分类。
Specifications
- 目录号
- BX50021
- 克隆号
- BP6026
- 阳性对照
- 乳腺癌
- 亚细胞定位
- 细胞核
- 组织类型
- FFPE
- 修复方式
- HIER
- 稀释比
- 1:100-1:200
- 规格
- 100μl/vial, 1ml/vial
- 用途
- RUO
Reference
1.Stein B, et.al, Mol Cell Biol. 1995 Sep;15(9):4971-9.
2.Saville B, et.al,J Biol Chem. 2000 Feb 25;275(8):5379-87.


